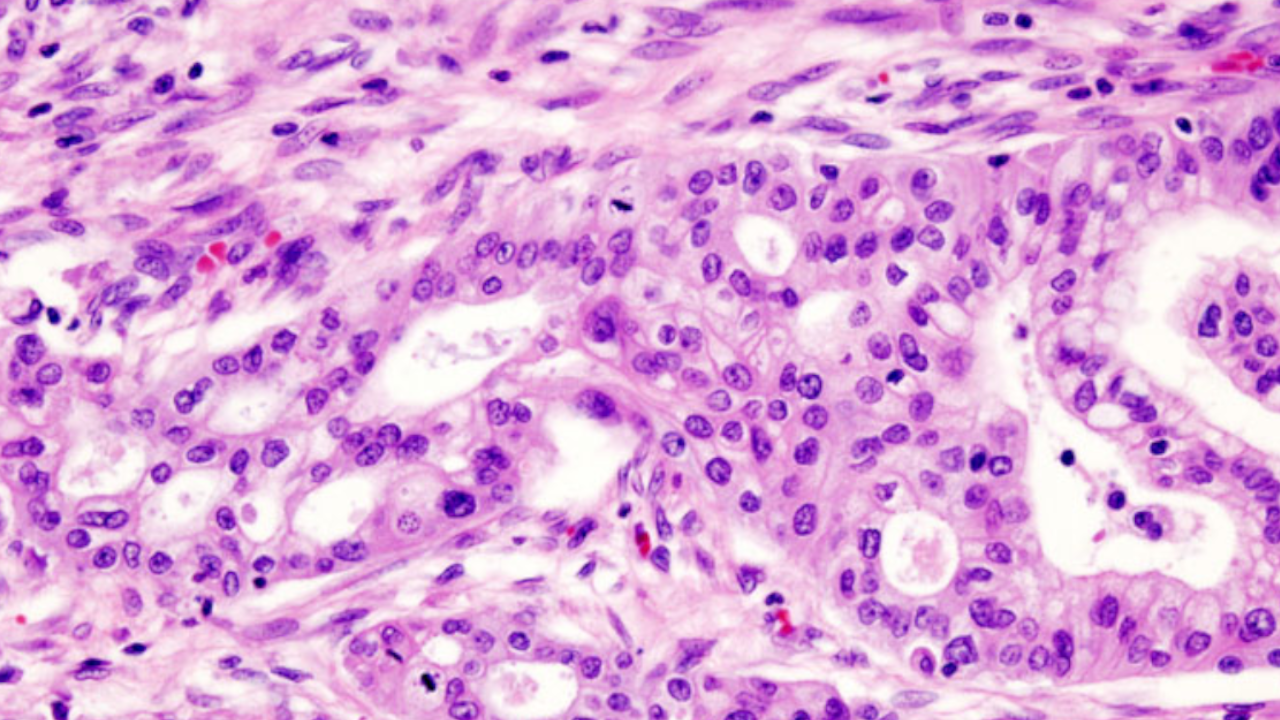

Un gruppo di ricerca dell’IEO di Milano ha affinato l’identikit dei due tipi principali di cellule che costituiscono questo tipo di cancro, scoprendo un ruolo importante per la proteina MYRF nel tipo cellulare più differenziato.
Uno dei motivi per i quali il tumore del pancreas è particolarmente difficile da curare è l’elevato livello di complessità della malattia, dovuto alla presenza di tipi differenti di cellule tumorali non ancora del tutto caratterizzati. In linea di massima, le cellule del tumore del pancreas possono essere di due tipi: cellule differenziate, che assomigliano a quelle dell’organo maturo, e cellule indifferenziate, molto diverse da quelle pancreatiche sane. Conoscere in dettaglio entrambi i tipi di cellule è fondamentale per mettere a punto nuovi trattamenti mirati ed efficaci. Ora un importante passo in avanti in questa direzione arriva grazie ai risultati pubblicati su Developmental Cell di uno studio condotto dal gruppo di ricerca di Gioacchino Natoli all’Istituto europeo di oncologia (IEO) di Milano.
Già da diversi anni il gruppo di ricerca guidato da Natoli si occupa della caratterizzazione sistematica di questi due tipi cellulari: grazie al prezioso sostegno di Fondazione AIRC, è stato ora messo in luce in particolare il ruolo di una proteina chiamata MYRF, un fattore di trascrizione che modula l’espressione di geni coinvolti nella secrezione di proteine. I ricercatori hanno scoperto che le cellule tumorali più differenziate sono estremamente dipendenti da questa proteina, che le aiuta a contenere lo stress dovuto alla loro elevatissima attività di secrezione proteica. Eliminando MYRF, le cellule tumorali più differenziate cominciano a manifestare segni di stress e riducono il proprio tasso di proliferazione. Un’osservazione che fa pensare a MYRF come a un possibile nuovo bersaglio terapeutico almeno per questa variante cellulare, anche se Natoli invita alla prudenza. “Se e come eventuali inibitori di MYRF possano diventare un farmaco è ancora tutto da dimostrare.” Quello che conta, per ora, è aver approfondito in modo significativo la conoscenza del “nemico”.
Gli esperimenti che hanno permesso di ottenere questi risultati sono stati condotti sia con cellule in coltura sia con topi di laboratorio nei quali sono stati trasferiti tumori di diretta derivazione umana. “Le colture cellulari sono utilissime per alcune osservazioni, ma a un certo punto diventa necessario passare agli animali di laboratorio, perché la complessità della malattia, anche rispetto all’interazione tra i diversi tipi cellulari che la compongono, è difficilmente riproducibile altrimenti”. Certo, anche gli esperimenti con gli animali – come per definizione tutti gli esperimenti in cui si analizzano alcune variabili – hanno dei limiti, ma per Natoli rappresentano comunque la migliore approssimazione oggi disponibile di come il tumore del pancreas si comporta negli esseri umani.
Immagine: Histopathology of pancreatic tissue in a mature cystic (Wikimedia)